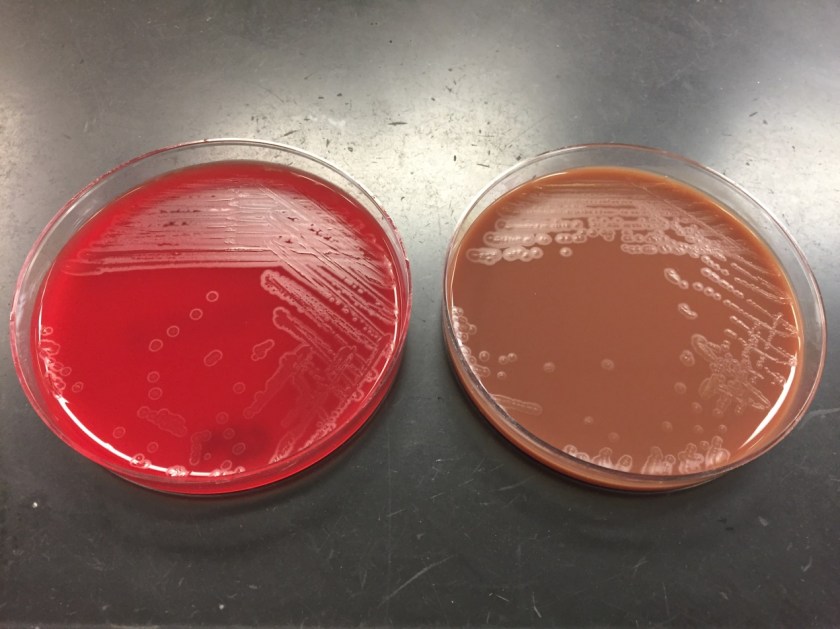
eikcor1

Case History
A 10 year old Caucasian male presented to the pediatric emergency department due to significant pain in his right knee with exposed hardware. His past medical history was noteworthy for Perthe’s Disease, a condition leading to avascular necrosis of the femoral head. In addition, he is affected by an autosomal dominant congenital disorder and has had ischemic strokes in the past. Recently, he had surgery performed on multiple joints to correct abnormalities and they were complicated by dehiscence & infection with methicillin sensitive Staphylococcus aureus. On current admission, his mother reported he has been afebrile and was consistently taking cephalexin to treat the above infection. He was taken to the operating room for incision & drainage and hardware removal of the knee. Bacterial cultures were collected at the time of surgery and he was started on IV clindamycin.
Laboratory Identification

On direct Gram stain, there was no organisms seen and rare white blood cells. Initially, there was no growth at 24 hours, but two morphologies were observed on the second day. The first organism was identified as the S. aureus that was previously isolated from this site. The second organism was clear with spreading colonies that pitted the agar (Image 1). A distinct bleach like odor was observed. There was no growth on MacConkey agar even though the Gram stain showed gram negative rods, making this organism most likely to be classified as fastidious (Image 2). Benchtop biochemical tests were negative for catalase and positive for oxidase. MALDI-TOF mass spectrometry identified the isolate as Eikenella corrodens.
Discussion
Eikenella corrodens is a fastidious Gram negative rod that is a member of the HACEK family. It is considered normal flora in the oral cavity and possibly the gastrointestinal tract of humans. Infection results from these endogenous sources and can be the result of poor oral hygiene, mucositis or dental procedures. E. corrodens causes juvenile and adult periodontitis and is commonly implicated in bacteremia and infective endocarditis, particularly in IV drug users who lick needles prior to injection. Infections of the abdomen, bones/joints and brain are less common.
In the laboratory, E. corrodens is slow growing and is usually present as clear, spreading colonies after 48 hours incubation at 37°C in 5% CO2 on blood and chocolate agars. A unique feature of the organism is that it pits or corrodes the agar, lending to its species name. Also, E. corrodens produces a bleachy smell due to the production of hypochlorite. It does not grow on MacConkey agar despite the fact it is a Gram negative rod. Biochemical tests are negative for catalase, positive for oxidase and negative for indole. Automated instruments and MALDI-TOF mass spectrometry are both able to identify E. corrodens with confidence.
Susceptibility guidelines can be found in the 3rd edition of the CLSI M45 document. In general, E. corrodens is susceptible to penicillin, board spectrum cephalosporins, carbapenems, azithromycin and fluoroquinolones. Resistance to narrow spectrum cephalosporins, macrolides and clindamycin has been documented. In general, susceptibility testing should be performed on E. corrodens when it is isolated from a normally sterile site or is identified in pure culture. Beta lactamase testing is recommended routinely on E. corrodens, and if positive, the isolate is resistant to penicillin, ampicillin and amoxicillin. In the case of bite wounds caused by E. corrodens, susceptibility testing may not be necessary if it is treated with amoxicillin-clavulanate acid (Augmentin) due to a high probability of susceptibility to this antibiotic.
In the case of our patient, he responded to the antibiotic therapy used to treat his S. aureus and E. corrodens infections and healed well. He was placed on long term oral antibiotic therapy until additional hardware is able to be removed at a future date.

-Rim Alkawas, MD, is a first year Anatomic and Clinical Pathology resident at the University of Mississippi Medical Center.

-Lisa Stempak, MD, is an Assistant Professor of Pathology at the University of Mississippi Medical Center in Jackson, MS. She is certified by the American Board of Pathology in Anatomic and Clinical Pathology as well as Medical Microbiology. She is the director of the Microbiology and Serology Laboratories. Her interests include infectious disease histology, process and quality improvement and resident education.